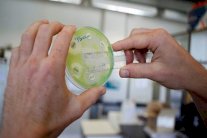
كشف البكتيريا شديدة المقاومة بأقل من ساعة

&
أظهرت اختبارات طبية ان بكتيريا تسبب الغنغرينا يمكن ان تساعد في علاج المصابين بالسرطان في مرحلة متأخرة من المرض بعد فشل كل الخيارات الأخرى. &
وتوصلت اختبارات أُجريت على نوع جديد من "العلاج البكتيري" للتأكد من سلامته ان الأورام السرطانية التي أصبحت مقاومة للعلاجات الأخرى إنكمشت وتحولت الى أورام نخرية لدى حقنها بغبيرات بكتيرية ، كما أفادت صحيفة الاندبندنت في تقرير. &
وقال التقرير ان أطباء في جامعة تكساس الأميركية استخدموا سلالة من بكتريا كلوستريديوم ديفيسيل بعد تعديلها لتكون غير ضارة بالبشر. &
وتحتاج هذه السلالة التي تُعرف باسم كلوستريديوم نوفي ـ إن تي الى بيئة واطئة الاوكسجين جداً للبقاء ، الأمر الذي يعني انها لن تنمو في النسيج السليم ذي الامداد الجيد من الدم ولكن الأورام الكثيفة ، المتنامية بسرعة تكون مضيفاً أمثل لها. &
ونقلت صحيفة الاندبندنت عن الدكتور فيليب جانكو من مركز اندرسن لأبحاث السرطان في جامعة تكساس قوله ان بكتيريا كلوستريديوم نوفي ـ إن تي باستغلالها الفوارق الموجودة بين النسيج السليم والنسيج السرطاني تمثل علاجاً دقيقاً جداً ضد الأورام الخبيثة يمكن ان يهاجم سرطان المريض على وجه التحديد. &
ويمكن ان تصبح هذه البكتيريا قوية جداً بالارتباط مع جيل جديد من علاجات السرطان يُعرف باسم العلاجات المناعية التي تحفز جهاز المناعة لإكتشاف الأورام واستهدافها. &
وقُدمت نتائج هذه الاختبارات في المؤتمر الدولي للعلاج المناعي ضد السرطان المنعقد في نيويورك. &
وتتطلب العلاجات الطبية الجديدة جولات متعددة من الاختبار على البشر أولا للتأكد من سلامتها ثم لإثبات مفعولها الثابت في تحسين فرص العيش بين مجموعات كبيرة من المرضى. &
وأُجريت الاختبارات الجديدة على 24 مريضاً بحقنهم بما بين 10 آلاف و3 ملايين غبيرة بكتيرية بعد أن أصبحت أورامهم السرطانية الصلبة مقاومة للعلاج الكيمياوي التقليدي والعلاجات الأخرى. &
وقال الدكتور جانكو ان النتائج الأولية تبين ان هذه البكتريا قادرة على تفعيل رد جهاز المناعة بالاضافة الى تدمير الورم. &
عبد الاله مجيد
أعدت "ايلاف" هذا التقرير بتصرف عن "الاندبندنت". &الأصل منشور على الرابط التالي
https://www.independent.co.uk/news/health/cancer-treatment-bacteria-gangrene-therapy-sarcoma-melanoma-immunotherapy-chemo-texas-university-a8561076.html
&

التعليقات